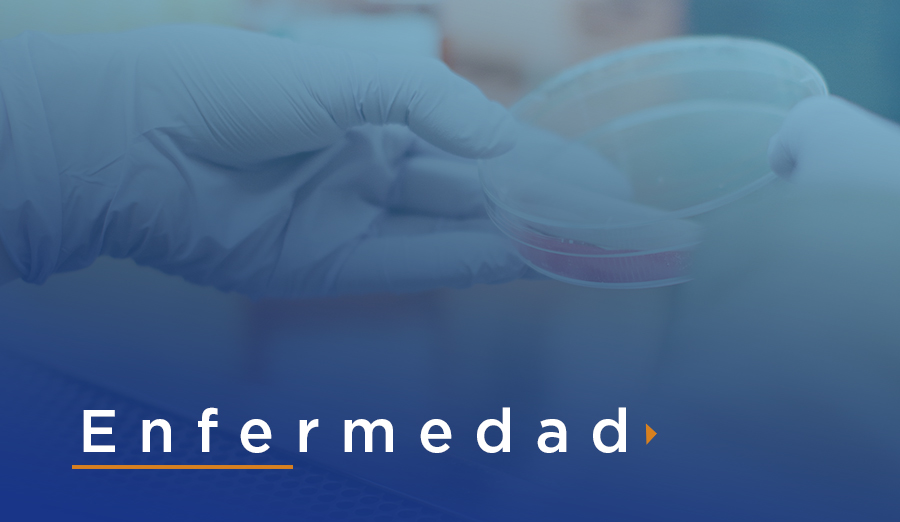

La edad:
El dolor de espalda es más común a medida que se envejece, a partir de los 30 o 40 años.


Muchos de nosotros nos hemos acostumbrado a sentir esa sensación molesta en nuestra espalda que NO ES NORMAL, pero creemos que lo es; ya sea por la edad, por la carga de trabajo que tenemos o por algún accidente que tuvimos en nuestra vida.
¡Tengamos una vida de calidad
y mejoremos juntos!
Comienza de pronto después de un accidente, una caída o al levantar objetos pesados. Es el tipo más común y dura menos de seis semanas.
Puede presentarse rápido o poco a poco y es de larga duración.
Además de las consecuencias físicas, el dolor de espalda crónico influye en otros aspectos de la vida, como los hábitos de sueño y el estado de ánimo general.

Cuanto más tiempo retrases el cuidado de tu dolor de espalda, más riesgo podrías tener de sufrir daño duradero y padecer consecuencias negativas en tu día a día.
Si crees que el dolor de espalda, sea cual sea su origen, está afectando a tu vida y te está molestando, es importante que hables con tu médico.







Gracias por su confianza
El Dr. Luis Cárdenas es excelente, para mí el mejor. Gracias por las atenciones, por siempre recibirme con tanta alegría y amabilidad. ¡Sin duda en CIFO son los mejores! Gracias por todo.
A pesar de que no es algo positivo tener un esguince, me encantó la experiencia de venir a CIFO y como me trataron cada uno de las personas aquí dentro. Muchas gracias por todo
Familias felices
Años de experiencia
Sucursales

San José del Cabo

Cabo San Lucas

Hospital H+
